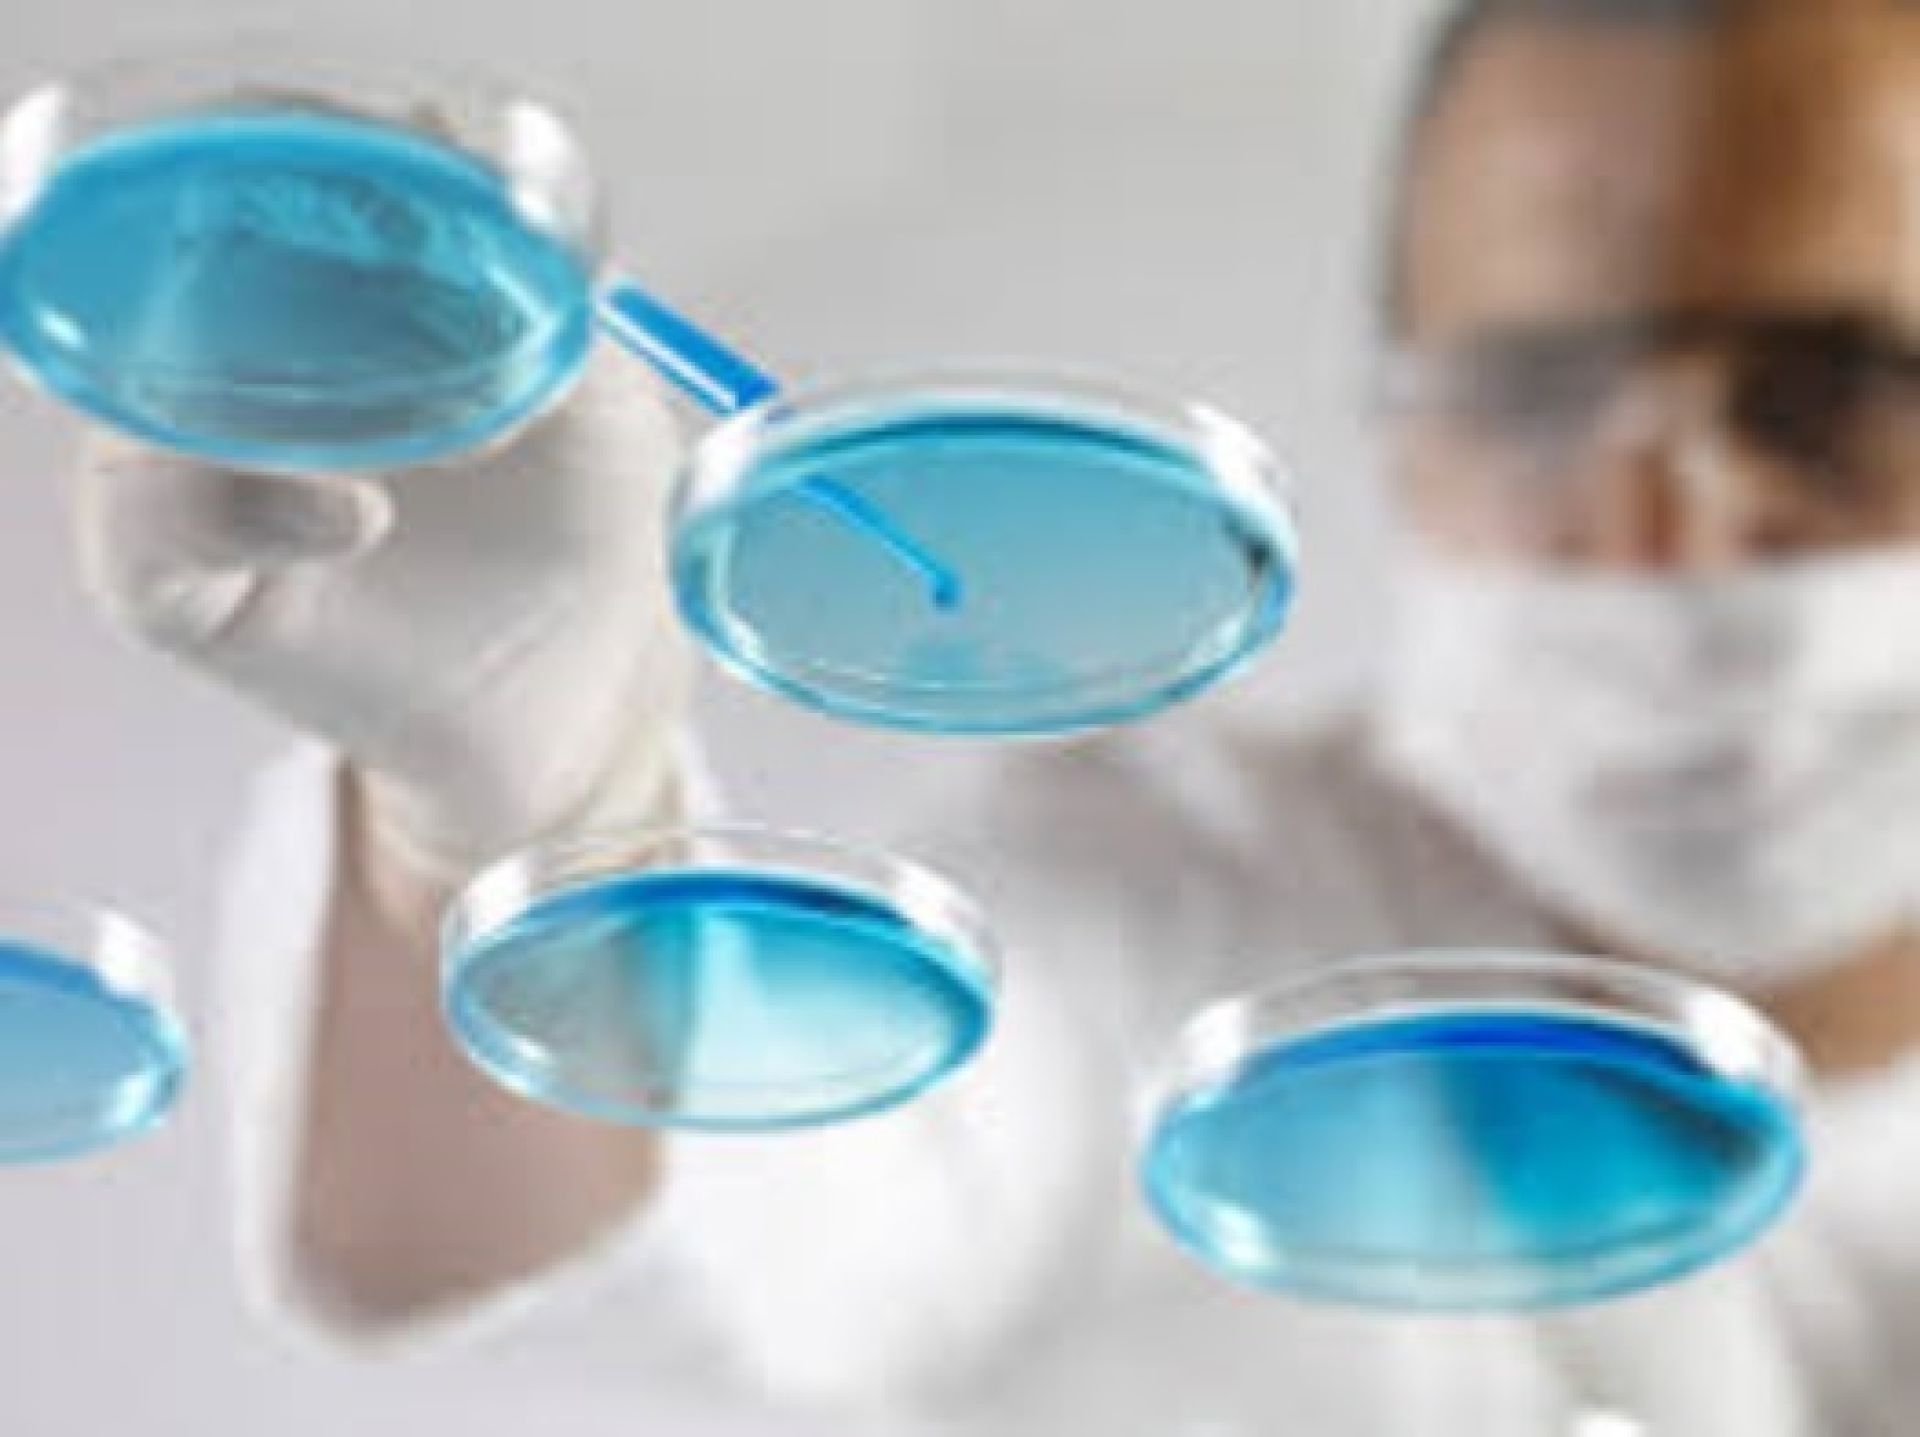

Los innovadores estudios que realizan jóvenes científicos de Farmacia
Tres alumnos se adjudicaron el IV Concurso de Valorización de la Investigación, perteneciente al Fondo de Fomento al Desarrollo Científico y Tecnológico de CONICYT.
El tratamiento de infecciones intrahospitalarias con la creación de una innovadora biotecnología generada a partir de una bacteria marina; una prometedora molécula que proyecta la solución para tratar la obesidad sin efectos cardiovasculares; y producir lácteos enriquecidos con fibra dietética procedente de residuos vegetales sólidos; son las tres novedosas ideas que se adjudicaron los fondos de la primera etapa del IV Concurso de Valorización de la Investigación (VIU), perteneciente al Fondo de Fomento al Desarrollo Científico y Tecnológico (FONDEF) de CONICYT.
Lideran estas investigaciones tres estudiantes de la Facultad de Farmacia, quienes se mostraron sorprendidos tras ser los únicos ganadores de la Universidad de Valparaíso, de acuerdo a lo informado por CONICYT.
Tal como se explica en el sitio web del Fondef, estos fondos concursables están dirigidos a alumnos de pre y postgrado que estén realizando o hayan terminado sus memorias o tesis en universidades chilenas acreditadas. Su objetivo es promover el emprendimiento de los alumnos en asociación con sus profesores guías y sus universidades, para la creación de nuevas empresas o negocios basados en los resultados de sus propias tesis.
Es así como Pedro Espinosa, egresado de química y farmacia, quien trabaja en el Laboratorio de Neuroquímica y Neurofarmacología, bajo la guía del doctor Ramón Sotomayor, desarrolló el proyecto "Una nueva herramienta farmacológica para tratar la obesidad con disminuido efecto cardiovascular".
Su línea de investigación es probar nuevas moléculas y caracterizar su efecto a nivel de sistema nervioso central. “Hemos visto moléculas que tienen un efecto muy interesante a nivel del cerebro, sin embargo no tendrían efecto a nivel cardiovascular según estudios in vitro. Estoy muy agradecido de las oportunidades que se me han dado y por lo mismo quisiera motivar al resto de los estudiantes que están partiendo en el camino de las ciencias. Para entrar a trabajar en Investigación lo más importante es atreverse, preguntar, relacionarse con los profesores y ser responsable y perseverante, eso es lo principal”, afirmó.
Por su parte Natalia Romo, también químico farmacéutico, quien llevó a cabo su investigación en el Laboratorio de Biotecnología Microbiana bajo la tutoría del doctor Alejandro Dinamarca, desarrolló un sistema de alerta temprana de patógenos en el aire para la prevención de infecciones intrahospitalarias que denominó AMBI.
En nuestro país se registran aproximadamente 70 mil infecciones intrahospitalarias anuales, y se estima que cada una se prolonga (en promedio) por diez días. Esto significaría 700 mil días cama y un costo para el país de 70 millones de dólares, según da cuenta el Informe de la Vigilancia de Infecciones Intrahospitalaria del Ministerio de Salud. AMBI es un sistema que permitirá detectar en tiempo real y en forma temprana los agentes infecciosos presentes en los hospitales, a través del análisis de muestras de aire
“Es muy gratificante adjudicarme este proyecto, es un lindo desafío que tomo con mucho orgullo y responsabilidad, sin duda voy a poner todo mi esfuerzo y dedicación a esta etapa que recién está comenzando”, aseguró.
Finalmente Nicole Valencia, nutricionista, que actualmente cursa el Magister en Ciencias mención Bioactividad de Productos Naturales y de Síntesis, que imparte la misma Facultad, junto a su profesora guía, doctora Jacqueline Concha, académica que dirige el Laboratorio de Biofarmacia, fundamentó su tesis de pregrado en la elaboración de matrices alimentarias con incorporación de fibra dietética soluble e insoluble obtenidas de residuos agroalimentarios usualmente no aprovechados.
El producto comercial que se obtendría tras este estudio mejoraría sustancialmente la dieta de la población chilena, que es baja en frutas y verduras (Encuesta Nacional de Salud), aumentando el consumo de éstas de una forma diferente y novedosa, ya que se podrá utilizar la materia prima completa, tanto la pulpa para el sabor, como los residuos para fibra dietética.
“Está adjudicación es una gran oportunidad que me permitirá trabajar en lo que planteé en mi tesis de pregrado y en la que siempre quise proyectarme. Como nutricionista este fondo me permitirá involucrarme en producción alimentaria y en un emprendimiento, que quizás por mi sola hubiera llevado mayor tiempo y sería difícil de lograr”, concluyó.




